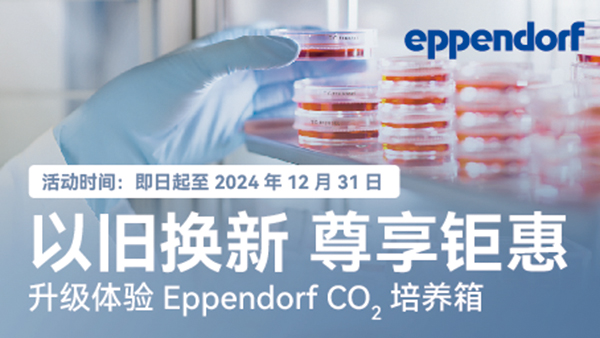
新闻图片1

17 年
手机商铺
公司新闻/正文
170 人阅读发布时间:2024-09-10 16:56
细胞培养的每一个细节都可能影响实验的成败,所以CO2培养箱的设计工艺也在不断发展。我们特别推出了Eppendorf CO2培养箱以旧换新优惠活动,旨在为您提供稳定均一,安全无污染的细胞培养环境。即日起至2024年12月31日,任意一台进口品牌CO2培养箱旧机型可换购Eppendorf CellXpert C170 CO2培养箱一台,每台享人民币 5000元抵现优惠。请扫描下方二维码填写换新意向信息,如符合换新条件,将由Eppendorf工作人员为您提供专属服务并获得精美礼品一份,快让你的细胞住进洁净无忧的新家吧!
